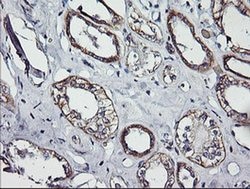
ERBB2 Monoclonal Antibody (OTI4F10), TrueMAB , OriGene 100 &mu;L; Unconjugated:Antibodies,

Learn More
ERBB2 Monoclonal Antibody (OTI4F10), TrueMAB™, OriGene
Mouse Monoclonal Antibody
Brand: Origene Technologies TA503443

Description
ErbB2 (Her2/neu) is a 185 kDa transmembrane receptor tyrosine kinase from the EGFR (epidermal growth factor receptor) family that regulates biological responses such as cell growth, differentiation, and tissue development. ErbB2 has no ligand binding domain of its own and cannot bind growth factors. However, ErbB2 does bind tightly to other ligand-bound EGF receptor family members to form a heterodimer, stabilizing ligand binding and enhancing kinase-mediated activation of downstream signaling pathways, such as those involving mitogen-activated protein kinase and phosphatidylinositol-3 kinase. Autophosphorylation of tyrosine 1139 on ErbB2 allows binding of Grb2 and the Src SH2 domain, which allows activation of the Ras, Raf, ERK1/2 and JAK/STAT signaling pathways, respectively. Alternative splicing of ErbB2 results in several transcript variants, some encoding different isoforms and others that have not been fully characterized. In humans, the gene encoding ERBB2 is present on chromosome 17. Amplification and/or overexpression of the ErbB2 gene has been reported in ovarian tumors, breast, lung and skin cancer.Specifications
| ERBB2 | |
| Monoclonal | |
| Unconjugated | |
| ERBB2 | |
| CD340, HER-2, HER-2/neu, HER2, MLN 19, NEU, NGL, TKR1 | |
| Mouse | |
| Affinity Chromatography | |
| RUO | |
| 2064 | |
| -20° C, Avoid Freeze/Thaw Cycles | |
| Liquid |
| Flow Cytometry, Immunocytochemistry, Immunofluorescence, Immunohistochemistry (Paraffin), Western Blot | |
| OTI4F10 | |
| PBS with 1% BSA, 50% glycerol and 0.02% sodium azide | |
| P04626 | |
| ERBB2 | |
| Human recombit protein fragment corresponding to amino acids 676-1255 of human ERBB2 produced in HEK293T cell. | |
| 100 μL | |
| Primary | |
| Human | |
| Antibody | |
| IgG2a |
The Fisher Scientific Encompass Program offers items which are not part of our distribution portfolio. These products typically do not have pictures or detailed descriptions. However, we are committed to improving your shopping experience. Please use the form below to provide feedback related to the content on this product.